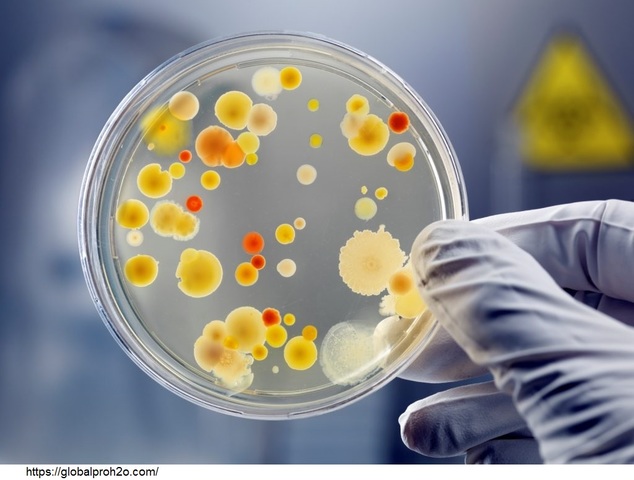
Investigaciones en los aspectos microbiológicos.

-
"El agua impura debe purificarse al ser hervida sobre un fuego, o que se calienta al sol, o sumergiendo una plancha calentada en él, o puede purificarse por filtración a través de arena y gravilla, y luego permitido enfriar."
-
Comenzó con el tratamiento interno del agua de la caldera utilizada para generar vapor.
-
La mayoría de ellas involucró el uso de taninos orgánicos naturales para el control de la escala de la caldera. Algunas patentes fueron el uso de fosfato disódico y del fosfato trisódico.
-
Se produjeron muchas explosiones de calderas, probablemente relacionadas con la fragilidad cáustica de los metales de la caldera.
-
La espuma y el arrastre de sólidos en el vapor se hicieron más frecuentes, la generación de dióxido de carbono a partir de la degradación del bicarbonato se identificó como una de las principales causas de la corrosión del condensado.
-
Se reconoció en general que la fragilización era causada por una combinación de estrés metálico y alta concentración de hidróxido de sodio.
-
El tratamiento primario fue el ajuste del pH con ácidos o alcalinos.
-
Se desarrolló índice de saturación de Langelier (LSI). Se introdujo un tratamiento umbral con hexametafosfato de sodio a unas pocas partes por millón.
-
Se realizó el primer estudio científico de neutralización de aminas para controlar la corrosión del dióxido de carbono en las líneas de condensado.
-
El nitrato de sodio comenzó a usarse para inhibir la fragilización en las calderas y se introdujo el programa coordinado de control de fosfato/pH.
-
Ryznar introdujo su índice de estabilidad para el agua de refrigeración.
-
Los programas de tratamiento químico interno para sistemas de calderas continuaron refinándose mediante el uso de agentes dispersantes sintéticos.
-
Los principales avances en el control de depósitos en los sistemas de agua de refrigeración. La introducción de diversos compuestos orgánicos sintéticos y naturales se generalizó.
-
En la coagulación con agua, se abogó por el uso del potencial zeta y se introdujo el uso de floculantes orgánicos sintéticos de aguas residuales industriales.
-
Los aspectos microbiológicos del tratamiento de agua de refrigeración también vieron avances. Se investigó el efecto de la actividad microbiológica sobre la corrosión, incluido el efecto de las bacterias reductoras de sulfato.
-
Se estudiaron las investigaciones de polifosfatos como inhibidores de la corrosión en sistemas de enfriamiento bajo variadas condiciones de temperatura, pH y transferencia de calor.
-
El tratamiento del agua de refrigeración se vio afectado por consideraciones ambientales.
-
El uso de polímeros en el tratamiento del agua de refrigeración progresó junto con una tendencia inicial a programas de tratamiento de agua de enfriamiento más alcalinos.
-
Los altamente efectivos inhibidores de la corrosión del agua de enfriamiento con cromato-fosfato-zinc fueron atacados por problemas ambientales y de salud y, en muchos casos, tuvieron que ser reemplazados con tratamientos de eficacia menos probada debido a consideraciones ambientales.
-
El uso de cromato fue inicialmente prohibido en aplicaciones HVAC y luego en todas las aplicaciones de torres de enfriamiento industriales por razones ambientales y de salud.
-
Aunque el molibdeno pertenece a la misma familia química que el cromato, no tiene el valor de pasivado u oxidación, por lo que se utilizó para complementar otros inhibidores de la corrosión y fue popular debido a su facilidad para realizar pruebas.
-
Debido a las preocupaciones ambientales, los programas de agua de enfriamiento "todos orgánicos" se volvieron populares, los cuales se basaron esencialmente en la química de los fosfonatos y los polímeros.
-
La AWT es un grupo de empresas independientes de tratamiento de agua que ofrece capacitación técnica de alto nivel, oportunidades de creación de redes, eventos educativos, asistencia de mercadotecnia, monitoreo legislativo, asistencia para el cumplimiento regulatorio y reputación.
-
El énfasis en la reutilización del agua se intensificó durante esta década y las tecnologías de membrana, incluidas la microfiltración, la ultrafiltración y la ósmosis inversa, se volvieron mucho más populares y asequibles.
-
Las principales compañías químicas de tratamiento de agua trataban de mantener márgenes relativamente altos al limitar el servicio de campo en el sitio y usar la automatización y el monitoreo.
-
Se hace énfasis en los programas que permiten ciclos de concentración altos para minimizar el uso de agua y la aplicación de aguas residuales en los sistemas de refrigeración.
Want to make a timeline like this?
Use Timetoast to turn dates, events, milestones, and phases into a clear visual timeline you can build and share. Timetoast is a timeline maker for work, school, research, and stories.